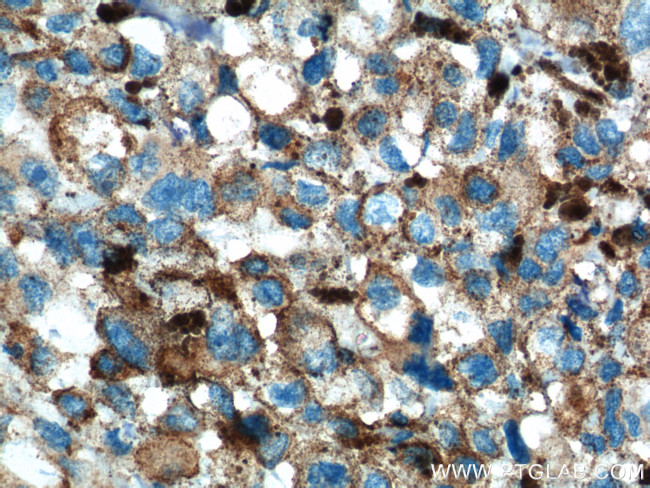
SLC45A2 Antibody in Immunohistochemistry (Paraffin) (IHC (P))

Search
Proteintech
SLC45A2 Polyclonal Antibody
{{$productOrderCtrl.translations['antibody.pdp.commerceCard.promotion.promotions']}}
{{$productOrderCtrl.translations['antibody.pdp.commerceCard.promotion.viewpromo']}}
{{$productOrderCtrl.translations['antibody.pdp.commerceCard.promotion.promocode']}}: {{promo.promoCode}} {{promo.promoTitle}} {{promo.promoDescription}}. {{$productOrderCtrl.translations['antibody.pdp.commerceCard.promotion.learnmore']}}
产品信息
10453-1-AP
已发表种属
宿主/亚型
分类
类型
抗原
偶联物
形式
浓度
规格
保存条件
运输条件
产品详细信息
Immunogen sequence: MGSNSGQAG RHIYKSLADD GPFDSVEPPK RPTSRLIMHS MAMFGREFCY AVEAAYVTPV LLSVGLPSSL YSIVWFLSPI LGFLLQPVVG SASDHCRSRW GRRRPYILTL GVMMLVGMAL YLNGATVVAA LIANPRRKLV WAISVTMIGV VLFDFAADFI (1-159 aa encoded by BC003597)
靶标信息
SLC45A2 is a melanocyte differentiation antigen that is expressed in a high percentage of melanoma cell lines. A similar sequence gene in medaka, 'B, ' encodes a transporter that mediates melanin synthesis. Mutations in this gene are a cause of oculocutaneous albinism type 4. The protein encoded by this gene encodes a melanocyte differentiation antigen that is expressed in a high percentage of melanoma cell lines. A similar sequence gene in medaka, 'B, ' encodes a transporter that mediates melanin synthesis. Mutations in this gene are a cause of oculocutaneous albinism type 4. Alternative splicing results in multiple transcript variants encoding different isoforms.
仅用于科研。不用于诊断过程。未经明确授权不得转售。